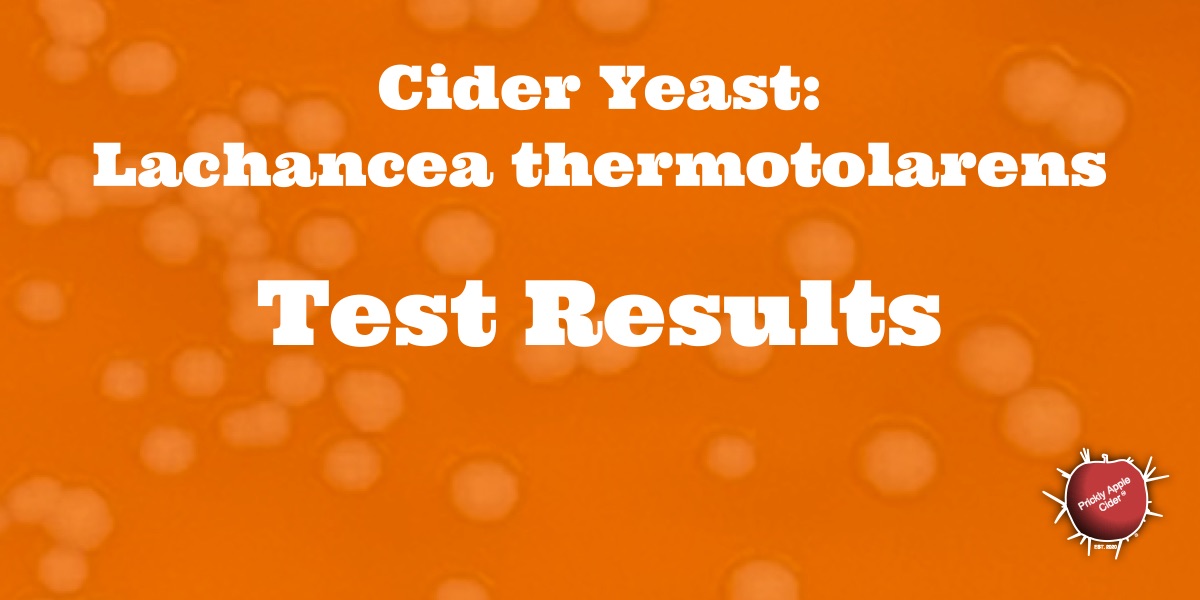
Non-Saccharomyces Yeast:  Lachancea thermotolarens&nbsp;Results
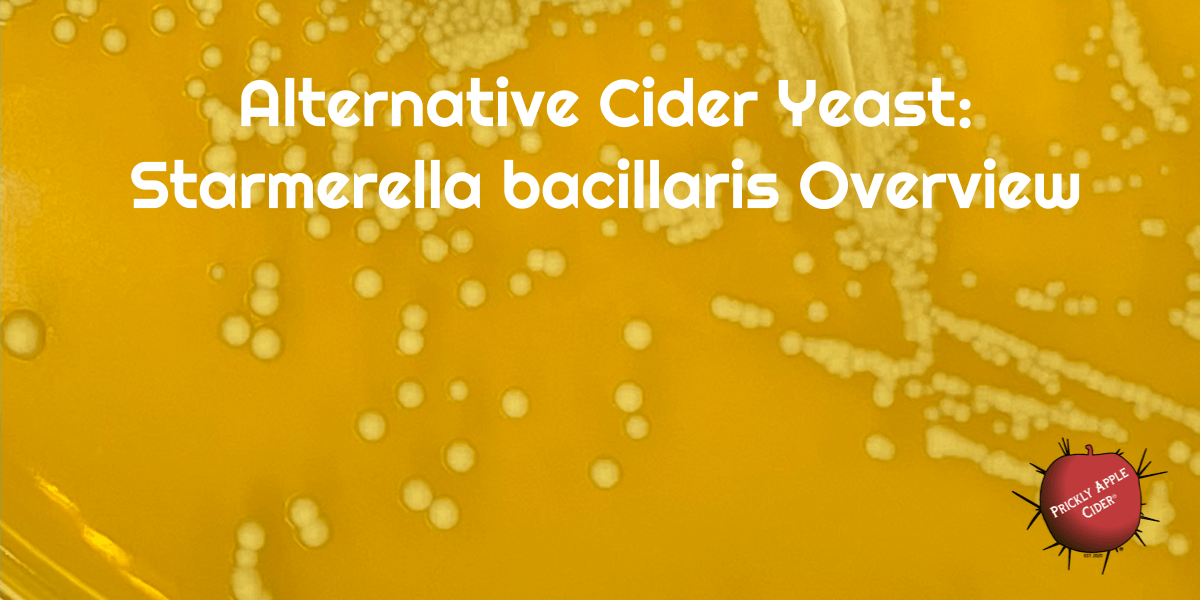
Alternative Cider Yeast: Starmerella bacillaris (Candida zemplinina)&nbsp;Overview

Have you ever wondered if you should really press apples for hard cider? What should you do to make a sweet hard cider? How can you tell the amount of tannins in an apple? What data should you document regarding your hard cider? How do you clean bottles and equipment for making hard cider? Isn’t cleaning and sanitizing cider making equipment the same thing? What’s the best way to clarify cider or should it be clarified? Do you need help troubleshooting a problem with your hard cider? What makes hard cider taste the way it does?
I have tried to provide information that answers these questions plus many more. I’ve organized the tips and information by section to make it easier to find pertinent information. Since I am always adding new tips, I thought this approach might be easier to use. Here are the current sections. Simple click on a button to open a page dedicated to that topic or you can scrolls down for all the tips and information.
Apples and Apple Processing Tips
Aging, Color, and Maturation Tips
Carbonation and Bottling Tips
Sweetness, Flavor, and General Methods
Yeast and Fermentation Tips
Non-Saccharomyces Yeast Tips
Filtering and Clarifying Tips
Cleaning and Sanitizing Tips
Trees and Orchard Tips
Did you enjoy these tips on making hard cider? Check out my book to learn more ideas and information on making and enjoying hard cider. It will help you develop a process that matches your desire and equipment. It will also show you how to pair cider with food to maximize your experience. You can find it as an eBook and a 7×10 paperback on Amazon or a 7×10 paperback on Barnes & Noble. Click on these Links to check them out.